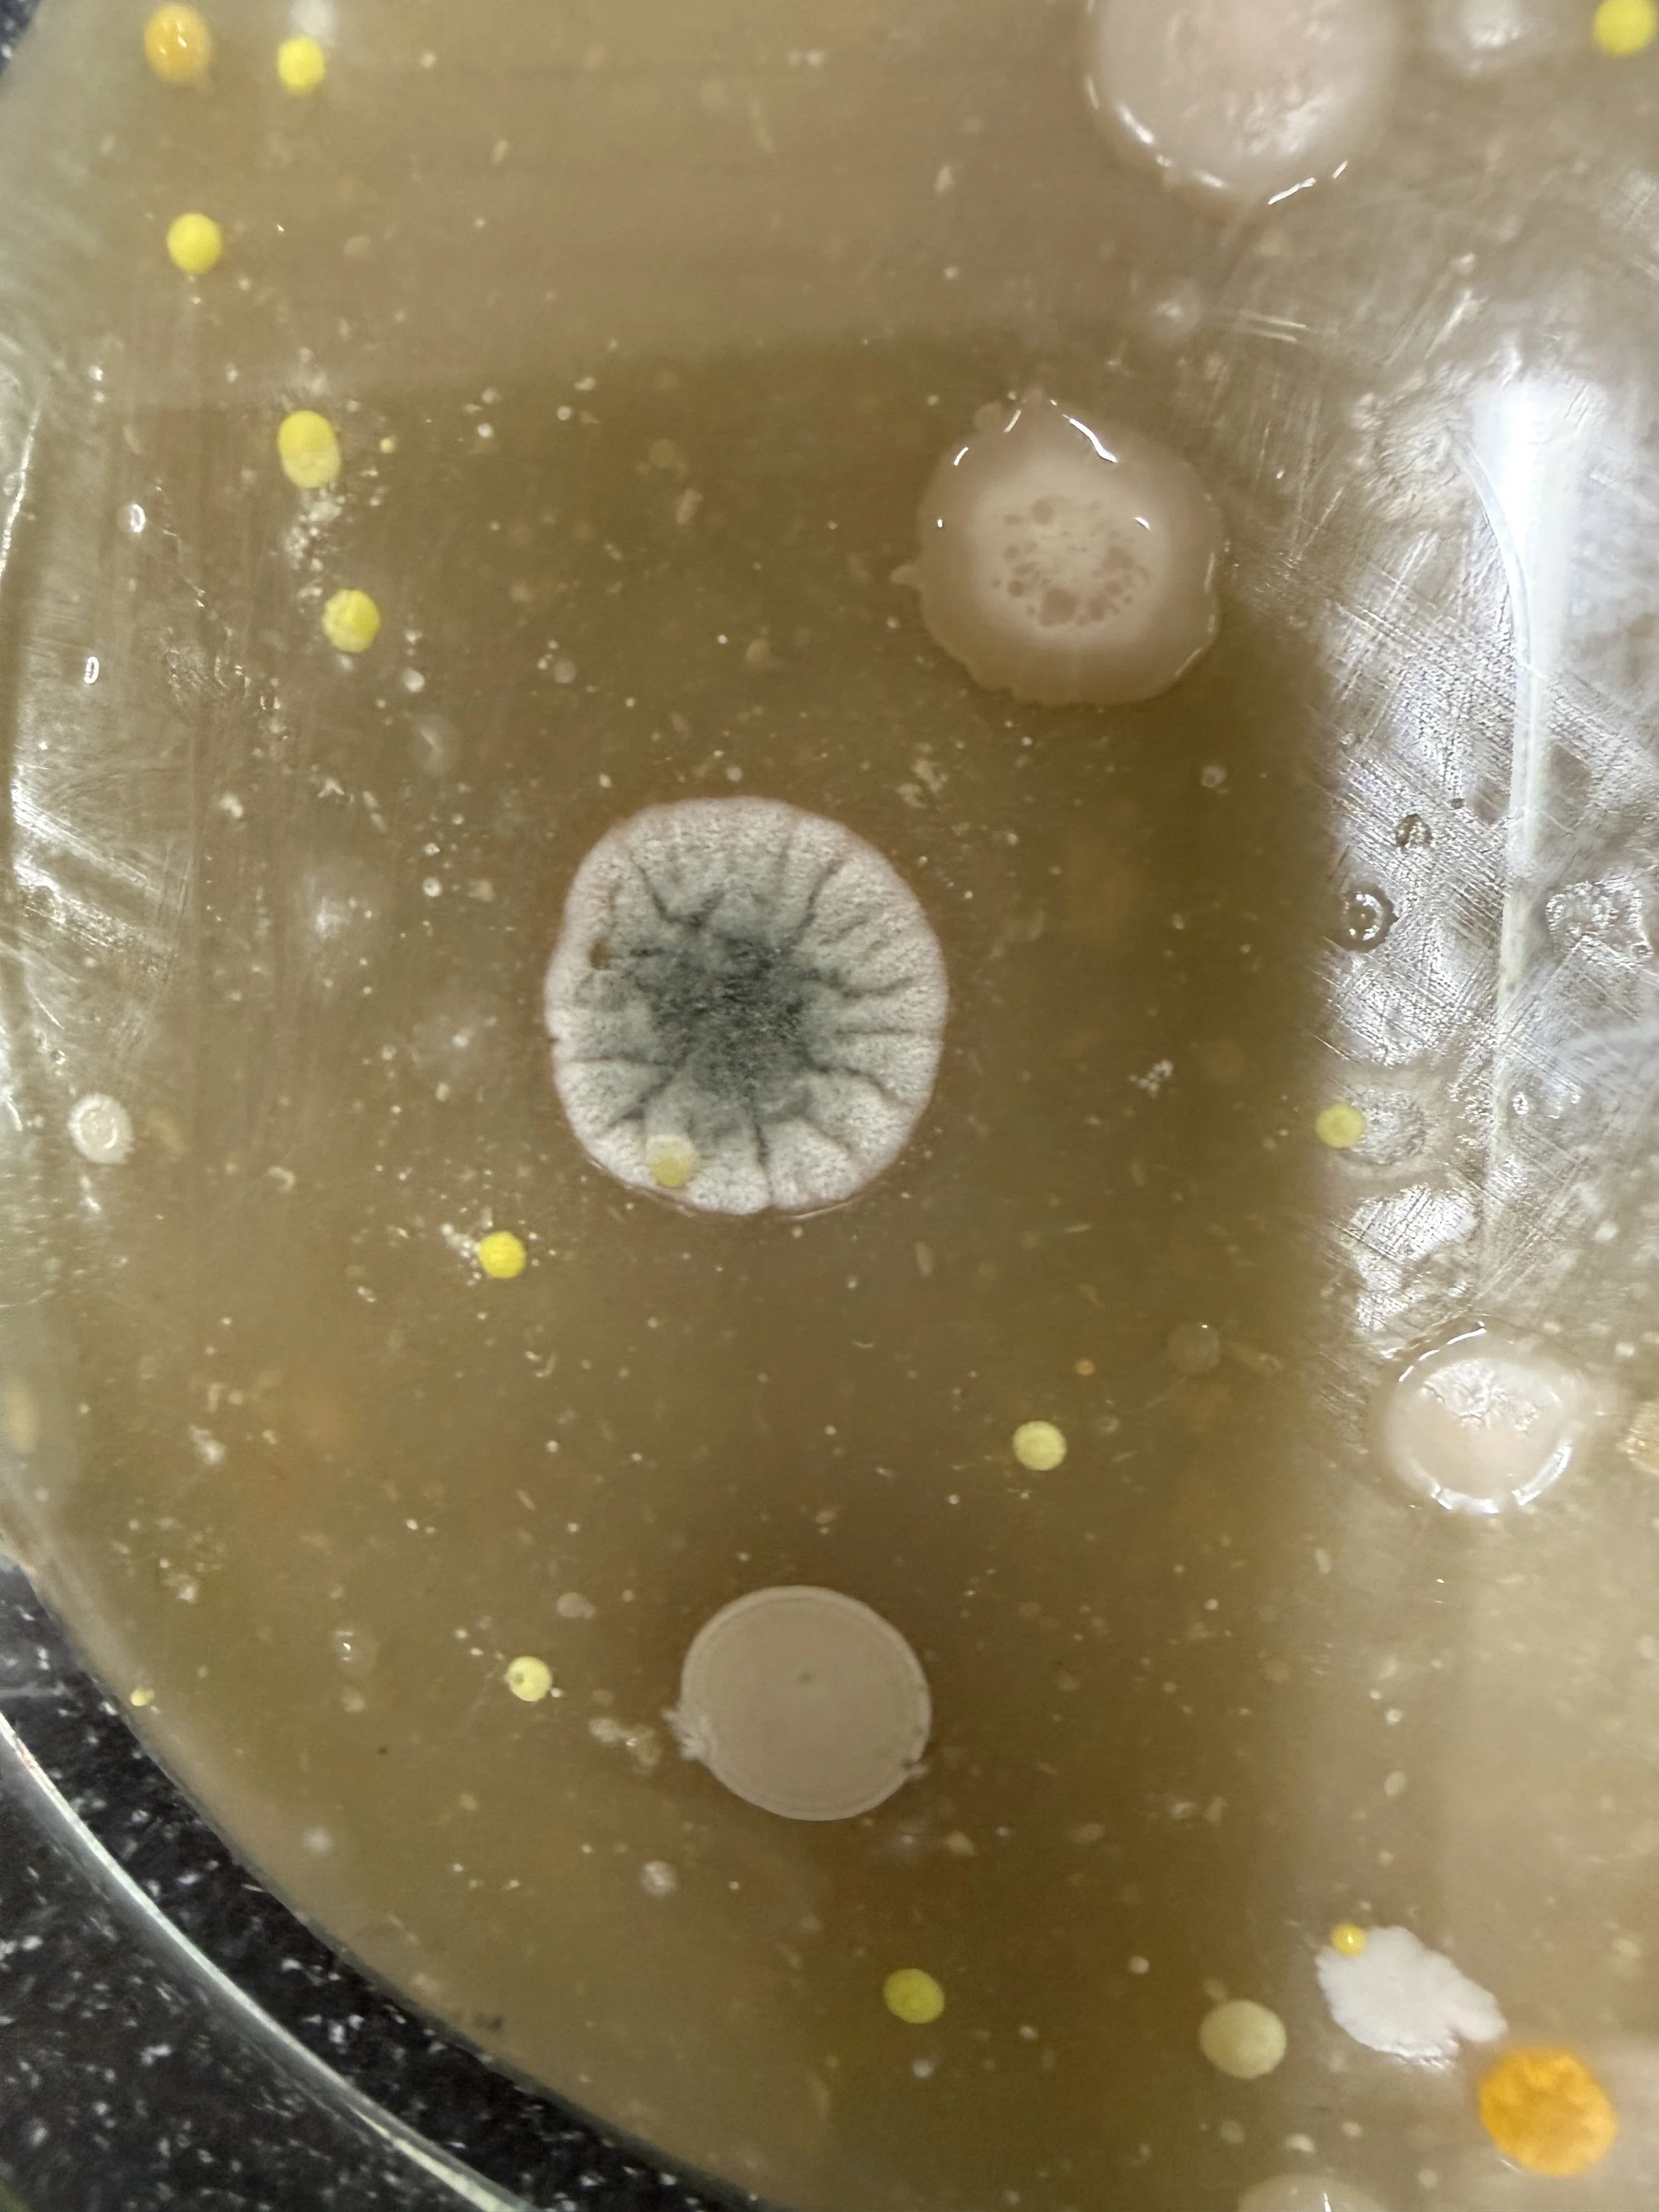
(NT) Experiment 1: Keime auf der Türe sichtbar machen

(BS) Bewegung und Sport in der Sekundarstufe I
Was ist, wenn der Sportunterricht nicht so funktioniert, wie man das im Studium lernt? … Hier teile ich meine Go-Tos.

Was ist, wenn der Sportunterricht nicht so funktioniert, wie man das im Studium lernt? … Hier teile ich meine Go-Tos.